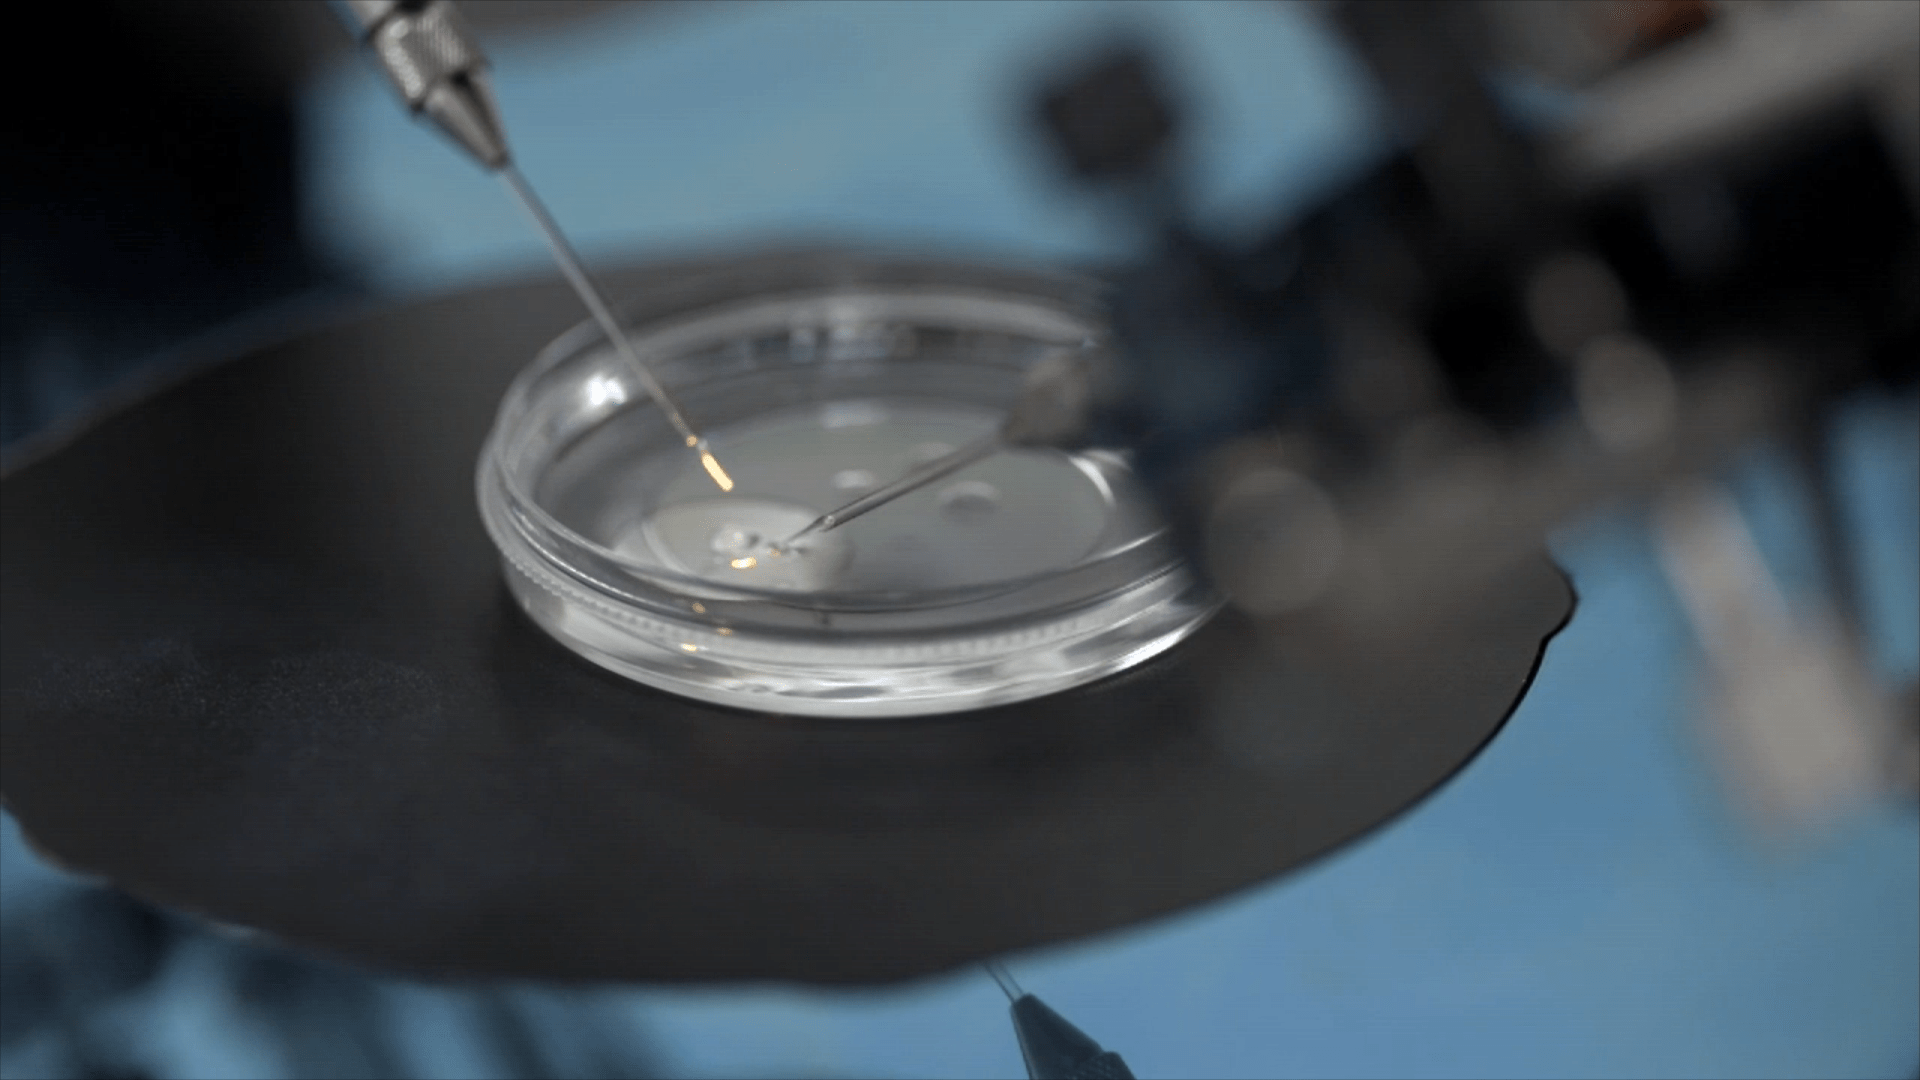
IVF Lite: A new strategy for managing poor ovarian response

E-Brochure - Download Now!

IVF Lite involves a soft stimulation protocol with the lesser amount of fertility drugs. When combined with Egg or Embryo Accumulation using the Cryotech Vitrification Technology (ACCU-VIT), it provides a very efficient and cost-effective alternative to conventional IVF. It is designed to retrieve only a few eggs in each ovarian stimulation cycle. Stimulation in this manner has been associated with better quality eggs and hence better quality embryos. In other words, it is a simpler treatment schedule with lower doses of drugs, fewer risks (from Multiple Pregnancy and Hyper-stimulation) and consequently reduces cost. IVF Lite goes easy on patient ovaries and easier on finances.

Generally, the aim is to grow fewer, but better-quality follicles. If you're in your forties and/or have an AMH level below 10 pmol/l, a mild IVF cycle may produce more viable eggs. Blasting your ovaries with heavy dosage of medication may do more harm than good. Think of blowing bubbles & blowing gently can lead to bigger and better bubbles. With mild IVF, the approach is the same: keep it light and gentle.
In the IVF Lite protocol, one or more Minimal Stimulation IVF cycles are carried out and all the resulting eggs or embryos are frozen using the Cryotech Vitrification technique (ACCU-VIT) to accumulate a sufficient number of eggs / embryos for a remote PGS (if indicated) and frozen thawed embryo transfer. In cost-conscious environments, IVF Lite is the only type of IVF that is going to be the future.
Instead of the high doses of fertility injections used in conventional IVF cycles, Clomiphene Citrate tablets, a low dose of fertility injections (Gonadotropins) and GnRH Antagonist injections are used in the softer IVF Lite stimulation protocol. Egg retrieval is planned 34-36 hours after the hCG trigger. All retrieved eggs / embryos are frozen and in a subsequently chosen month, the endometrium is prepared using estrogen tablets to increase implantation rates. In this month, if eggs were accumulated, then they are thawed and fertilized with husband's sperm and an Embryo Transfer is planned in this remote cycle. If embryos were accumulated, then they are thawed and an Embryo Transfer is planned in this remote cycle.
Today, we can offer IVF Lite to almost everyone requiring IVF. The groups which traditionally benefited from minimal stimulation IVF are Poor Responders, advanced age Patients (above age 40), women with multiple previous conventional IVF Failures and Hyper-responders (like patients with PCOS who go repeatedly into Ovarian Hyperstimulation). Today, because of the cost advantages & much higher success rates, we have extended the indications of IVF Lite to all patients requiring IVF/ ICSI.

Gentle ovarian stimulation protocols, such as IVF Lite, have several potential advantages over conventional IVF protocols, including less medication and fewer injections, producing fewer eggs, but eggs of higher quality. Patient acceptability of the milder stimulation protocols is better. IVF Lite gives pregnancy rates (PRs) comparable with conventional IVF in patients with a normal ovarian reserve. IVF Lite gives PRs much better than conventional IVF in advanced age patients, patients with previous conventional IVF failures, poor responders, and hyper-responders. In cost-conscious environments, IVF Lite is probably the type of IVF that is going to be the feasible option in the future.